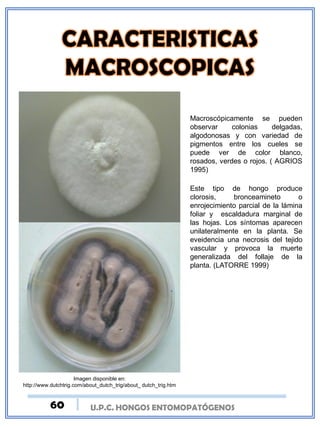
U.P.C. HONGOS ENTOMOPATÓGENOS
Imagen disponible en:
http://www.dutchtrig.com/about_dutch_trig/about_ dutch_trig.htm
Macroscópicamente se pueden
observar colonias delgadas,
algodonosas y con variedad de
pigmentos entre los cueles se
puede ver de color blanco,
rosados, verdes o rojos. ( AGRIOS
1995)
Este tipo de hongo produce
clorosis, bronceamineto o
enrojecimiento parcial de la lámina
foliar y escaldadura marginal de
las hojas. Los síntomas aparecen
unilateralmente en la planta. Se
eveidencia una necrosis del tejido
vascular y provoca la muerte
generalizada del follaje de la
planta. (LATORRE 1999)
60

Este documento trata sobre los hongos entomopatógenos y su uso en el control biológico de plagas. Explica que los hongos entomopatógenos son microorganismos que regulan las poblaciones de insectos de forma natural y pueden ser usados como agentes de control biológico. Describe algunas ventajas de los hongos entomopatógenos como alternativa al uso de insecticidas, y factores como la temperatura y humedad que afectan su efectividad. Además, presenta una clasificación general de











































![v
Como se hablaba anteriormente de que este genero teleomorfo se ha identificado
gracias a un orden taxonómico, este se presenta a continuación..
REINO: Fungi
PHILUM: Ascomycota
CLASE: Ascomycetes
ORDEN: Hipocreales
FAMILIA: Clavicipataceae
GENERO: Cordyceps
ESPECIE MAS ESTUDIADA: Cordyceps sinensis
BASIÓNIMO: Sphaeria sinensis
SINONIMO: Metarhizium, Bauveria, Isaria
ANAMORFOS:
• Cephalosporium donqchongxiacao
• Cephalosporium sinensis
• Chrysosporium sinense
• Hirsutella sinensis
• Mortierella hepiali
• Paecilomyces hepiali
• Scytalidium sp.
• Scytalidium hepiali
• Tolypocladium sinensis
*NOMBRES EN INGLES: Cordyceps mushroom,
Caterpillar Fungus
*NOMBRES EN JAPONES: Totsu kasu, Tochukasu
*NOMBRES EN CHINO: Hia tsao tong tchong,
dongchongxiacao [chongcao], traducción literal:
“gusano de invierno o planta de verano" antigua
china; moderna de china). (Holliday, 2004)
Imagen disponible en:
https://es.pinterest.com/pin/56055
7484845890461/?from_navigate=t
rue
Una de las especies mas estudiadas del genero
Cordyceps ha sido Cordyceps sinensis, podríamos
decir que es un parásito de artrópodos.
Su hábitat es de modo natural vive en la meseta de
las altas montañas del Himalaya (3.000-5.000 m) en
Tíbet, Nepal, India y algunas provincias de China.
U.P.C. HONGOS ENTOMOPATÓGENOS44](https://image.slidesharecdn.com/yalibrohongosentomopatogenos-160630004449/85/Ya-libro-hongos-entomopatogenos-44-320.jpg)